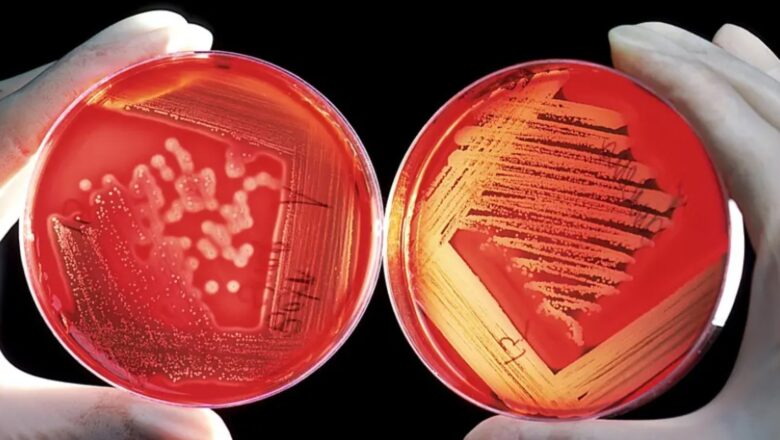
39 MILLONES DE PERSONAS PODRÍAN MORIR HASTA 2050 POR ESTA RAZÓN

UN GEN QUE HACE INVENCIBLES A LAS BACTERIAS SE PROPAGA POR TODO EL MUNDO
Un grupo de científicos ha alertado sobre un gen llamado 'npmA2', que dota a bacterias peligrosas de una resistencia total a los aminoglucósidos, un grupo de antibióticos vitales, y se está propagando por todo el mundo, según un artículo publicado este jueves en la revista Nature Communications.
Los investigadores, que analizaron casi 2 millones de muestras bacterianas, confirman que este gen actúa como un "pasaporte genético" que viaja en un fragmento móvil —cual "caballo de Troya"— y se incrusta en distintas bacterias, desde 'Clostridioides difficile', que causa infecciones intestinales, hasta 'Enterococcus faecium', responsable de contagios hospitalarios.
DE INTERÉS: LA EXPOSICIÓN A PESTICIDAS PUEDE AUMENTAR EL RIESGO DE CÁNCER DE INTESTINO
"El 'npmA2' es como un fantasma: casi...